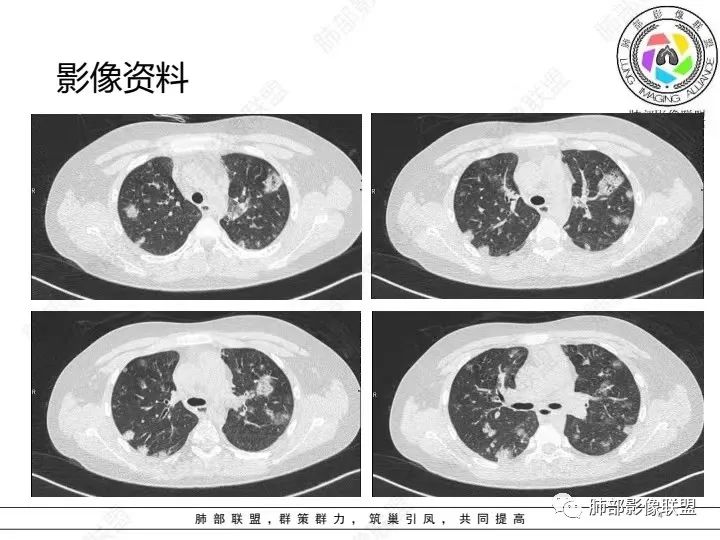

微信群讨论分析
摘星空竹子:
少年患者,游泳后发热畏寒,呼吸困难,两肺弥漫分布结节及磨玻璃影,考虑寄生虫感染,钩体病?
doctor:
考虑钩体病。
黄高晓:
外伤后与河水接触史,病灶分布随机,点晕征,淋巴低,CRP、降钙素高。休克血压。考虑感染性病变:钩端螺旋体病
淡淡&.清香:
两肺散在磨玻璃影,靠近胸膜多见,边缘有晕征,考虑感染性疾病,真菌感染
离殇??:
青少年,双肺多发结节斑片影,肝密度减低,有下水的经历,PCT太高,考虑感染性疾病,钩体病?金葡菌脓毒性栓子?
AAA张春雨:
患者河里游泳,受伤,发热,血压低到休克,呼吸困难三凹征,血气提示呼吸性碱中毒合并代谢性酸中毒且代酸占上峰,肺部表现既无明显出血的磨玻璃影(不符合钩体导致出血的特征)又无多发影内空洞(这点不符合金葡菌),是真菌感染的影像,河水属污水,故肺部表现为:尖端赛多孢子肺炎(这个菌感染重,死亡率高)!
蓝天白云:
青少年,河水不知道是否污染,气道分布斑片影,pct,crp高,g-杆菌,周围似见晕征,脓毒性肺栓塞,金葡,钩体感染
doctor:
肺部影像联盟晨读病例如果是非流动河水、溺水,考虑尖端赛多孢子菌。助攻一例如下:
 |
石榴木:
支持!加个屎肠球菌EFM肺炎
唐绍宏 通化市中心医院 呼吸科:
跳入河水中,左髋部疼痛,发热,无啰音,PCT>200,应该是血播金葡吧
武当王也:
@唐绍宏 通化市中心医院 呼吸科?请教一下,WBC不高,还考虑金葡?
唐绍宏 通化市中心医院 呼吸科:
社区获得性金葡,几乎都有杀白细胞毒素
wj:
肺部影像联盟晨读病例如果是非流动河水、溺水,考虑尖端赛多孢子菌。影像不是实性而是毛玻璃,不像金葡菌肺克。
唐绍宏 通化市中心医院 呼吸科:
白细胞不高的金葡,病灶边缘模糊
同样是血播的,金葡与肺克比较,金葡更趋于磨玻璃,肺克更趋于实变。给肝脏层面,作者的意思,就是告诉你没有肝脓肿。
段建民:
@唐绍宏 通化市中心医院 呼吸科? 金葡的话PCT也会这么高?
唐绍宏 通化市中心医院 呼吸科:
血播金葡可以的
风往北吹:
支持血播金葡。如果呛水引起的尖端赛多胞影像不支持。
左髋部疼痛,应该是个病因
武当王也:

这是尖端赛多孢子菌 |
宁静致远:
太多相同影像,下次看也不一定想得到。
武当王也:
学习了,溺水,特别是污水,要想到尖端赛多孢子菌
武当王也:
从放射科来讲:尖端赛多孢子菌和SPE阴影分布特点,如气道、还是随机分布,影像是否有区别?理论上尖端赛多孢子菌应该是气道,而血播金葡是随机,可惜我掌握不好。
请老师们指教
唐绍宏 通化市中心医院 呼吸科:
 |
| 血管来源 |
谢加平:
青少年,高处跳落游泳史,左侧盆部疼痛(怀疑皮肤损伤),畏寒发热,CRP和Pct显著升高,感染性休克表现(提示革兰阴性杆菌),双肺叶外周分布为主棉絮状结节及斑片影,GGO密度,边缘清,间质及实质改变,病灶内细网格影,见供血血管证,分布特点双肺叶Spe表现,考虑大肠杆菌导致血行感染,血培养检查!
赵国千:
男14岁,2天前下河游泳史,发热;两肺近外带可见磨玻璃密度影,边缘疑似晕征,结合实验室检查,符合感染,倾向真菌感染,支持肺钩端螺旋体病。
宇宙:
青少年,2天前下河游泳后畏寒发热,两肺外周胸膜下分布多发大小不等结节、斑片及磨玻璃,边缘模糊,考虑血流性感染,钩体?金葡?
放射小白:
男14岁,2天前下河游泳史,发热;两肺近外带可见磨玻璃密度影,边缘疑似晕征,结合实验室检查,符合感染,倾向真菌感染,支持肺钩端螺旋体病。
宇宙:
青少年,2天前下河游泳后畏寒发热,两肺外周胸膜下分布多发大小不等结节、斑片及磨玻璃,边缘模糊,考虑血流性感染,钩体?金葡?
飞鹰行动:
青少年男性,2天游泳后发热,双肺多发斑片状,结节状阴影,多分布肺外带,血道来源,部分病灶边缘可见磨玻璃影,患者有明显脂肪肝病史,考虑.感染性病变,金黄色葡萄球菌?钩体?肺克?
王江涛:
青少年,河沟游泳后急性发病,左侧髋部疼痛,双肺弥漫地方结节、斑片模糊影,CRP、PCT明显增高,考虑钩体病,鉴别血播金葡
王崇军:
PCt>200,脓毒血症了,有无皮肤损伤?诱因游泳,高处跳水,与水有关,影像为多发毛玻璃结节,有细网格样改变,内可见支气管影,所以是间质改变➕肺泡渗出;结节分布是随机分布,血源性。与临床相对应。感染性病变,pct不支持病毒排除。细菌,金葡?军团?需复查看看病情转变。有无三红三痛,如有,钩也可能。寄生虫待排。
许慧良:
考虑脓毒肺栓塞,革兰阴性菌感染,
了:
急性起病,游泳史,寒战发热,感染指标明显升高,胸部CT双肺多发磨玻璃影,实变,内可见支气管扩张,大致呈间质改变,随机分布,首先考虑感染性疾病。
蓝天白云:
青少年,河水不知道是否污染,气道分布斑片影,pct,crp高,g-杆菌,周围似见晕征,脓毒性肺栓塞,金葡,钩体感染
二妹柠檬���������:
晨读考虑脓毒肺栓塞,革兰阴性杆菌感染
若晗:
青少年,多发斑片影,有游泳史,伴CRP及PCT升高,首先考虑血源性葡萄球菌感染
꧁༺༽༾ཊ天涯ཏ༿༼༻꧂:跳水游泳史,急性症,畏寒发热,感染指标高,双肺多发片状、结节状密度增高影,部分边缘模糊,考虑感染性病变,脓毒肺栓塞?钩体、金葡、肺克感染?河水里,寄生虫也需排查
良孑:
年轻患者,急性起病,高处跌下,皮肤损伤,两肺胸膜下多发实变,边缘见磨玻璃影,部分实变呈楔形,实变内见粗网格影,部分实变见反晕征,综和病史考虑感染性病变,影像上符合脓毒性肺栓塞,支持血源性金葡菌感染,鉴一下COP
丽:
青年人,有游泳史,畏寒发热,双肺内及胸膜下多发实变,边缘见磨玻璃密度影,部分呈反晕征,内可见多发网格样改变,考虑感染性病变,金葡菌感染
放射线:
双肺叶结节及斑片状磨玻璃样密度,边缘清,外周分布为主,部分见供血血管,分布特点符合Spe表现,青少年,高处跳落游泳史,左侧盆部疼痛,畏寒发热,CRP和Pct显著升高,考虑血行感染,金葡?至于大家考虑的钩端螺旋体病和嗜水单胞菌不是太了解
瑞欣:
青少年发病急,高热,双肺多发斑片状磨玻璃影,边界模糊,以胸膜下为主,考虑感染性病变,金葡菌可能
月亮圆了!:
青年,游泳,盆骨处疼痛”原因?”,畏寒,发热,Pct明显升高。双肺多发斑片,结节影。胸膜下也有。考虑血播。金葡可能大
Yishion:
游泳,高处跳下盆骨疼痛,肺上血播及气道均有,符合感染性病变,吸入性病变,金葡菌肺炎要考虑
刘海玲:
 |
 |
分布,胸膜下和支气管束分布 密度以磨玻璃为主 ➕小叶内间隔增厚细网格征 出血?病毒性感染?
梁敉山眉山中医院呼吸内科:
这个还是考虑感染,影像不像吸入,结合临床,感染指标,阴性菌感染可能性大,铜绿?鲍曼不动?觉得军团影像不太支持,真菌影像也不太支持。
流心明智:
男,14岁,高处跳下,游泳后畏寒。胸部CT:两肺多发斑片影、结节影;沿支气管血管束分布,胸膜下也有;密度以GGO为主,部分为mGGO;边缘部分清楚,大部分模糊;内可见网格影、支气管充气征。考虑:SPE?肺水肿?鉴别淋巴瘤。
go and see:
病前有游泳史,河水以嗜水单胞菌为主,休克血压,PCT异常升高,考虑阴性杆菌,嗜水单胞菌可能性大。
病史中未提及重要鉴别诊断的症状:眼结膜充血、腓肠肌压痛、淋巴结肿大。
傅昌瑜:
CRP及PCT如此之高,是什么原因导致一个14岁的青少年白细胞计数不高呢?
南边分析
 |
 |
病史看。外伤。无溺水?
若尘:
支持血源性感染,金葡
南边:
体温不高。如果血源性金葡菌,哪里来的?首发感染源 在哪?
张钰(无锡九院呼吸科):
撞了,可能皮肤破了
南边:
我就怕脂肪栓塞

南边:
好像没提。
只是说左盆部疼痛,虽然CT说没事。
体温36.4。
奇怪,有些地方符合脓毒栓子,有些地方不符合啊。
不知道有无其他
吴婧南京市第一医院:
血播怎么会磨玻璃
南边:
早期脓毒栓子可以,楔形。
内部低密度影都符合

这些是典型的 |
 这种网格,没弄太清楚 这种网格,没弄太清楚 |
是否有二元的可能?看有无其他片,对比一下。
洪桥爱 湘西自治州人民医院感染科:
只有这一次CT片
姜春雷:
金葡菌怎么进血的
洪桥爱 湘西自治州人民医院感染科:
这个病例我也没有直接接触,是急诊科医生跟我提供的资料
推测应该是体表来源
南边:
问问有无其他地方伤口
吴婧南京市第一医院:
估计皮肤有破
洪桥爱 湘西自治州人民医院感染科:
当时的接诊医师没有考虑到血流感染的问题,病史没有强调外伤史
我接触到信息的时候,病人已故
南边:
查查还有没有其他影像资料
洪桥爱 湘西自治州人民医院感染科:
 |
 |
 |
 |
 |
 |
病例结果

洪桥爱:
病原出来之前,我也是偏向了G-菌,当时有个问题,这个患者没有基础疾病,他会从哪里来的G-菌感染?患者没有腹腔脏器感染征象;虽然PCT显著升高,常提示G-菌感染,但是严重休克、尿毒症也可以出现PCT的显著升高,这个病例入院是存在低血压(输液维持下),考虑存在休克,PCT升高考虑与休克有一定相关性;在考虑重症感染的情况下,白细胞正常,会想到分泌毒素细菌(杀白素),所以想到金葡,再结合病史可疑外伤史,推断金葡可能。
南边:
腹腔有源头也应该是肠道菌
琦遇:
血培养?还是痰培养?@洪桥爱 湘西自治州人民医院感染科?
洪桥爱:
血培养金葡
病例小结
影像与临床:
1.男性少年儿童,外伤后髋部疼痛,畏寒发热、咳嗽、呼吸困难。
休克血压。CRP、PCT明显升高。血气为代谢性酸中毒、呼吸性碱中毒。
2.影像上肺多发混合密度片影,随机分布,胸膜下分布优势,病灶边界大多隐约可辨,偏柔和,动脉血管影穿行,未见钙化、液化空洞、或明确气囊影,未见树芽征。
3.双侧胸腔未见积液。双肺门及纵隔未见增大淋巴结。
4.肝左右叶密度减低,未见结节影、块影或液化区。
综合分析:
1.特别强调:患儿有外伤史,骨关节疼痛,发热,病程短、进展迅速,症状一天之内接踵而至!
2.临床方面:发热,休克血压。CRP、PCT明显升高。血气为代谢性酸中毒、呼吸性碱中毒等等,会高度怀疑脓毒血症!
3.影像方面:双肺多发病灶,随机分布,且有相当部分沿胸膜下,是可以符合血流感染的。
4.责任病原菌:注意是儿童。孩童易外伤,易感染,皮肤粘膜感染、骨关节感染(如急性骨髓炎)是比较常见的,金葡菌感染是多见的,脓毒血症也以金葡为先。只是没有短期复查对比影像资料,不能观察到有无快速出现的气囊影或脓胸等(快速出现的气囊影尤具特征性)。
考虑到宿主因素,以及免疫相关,这个年龄的儿童,无论是G-杆菌还是真菌感染,并不常见。从病程发展看,也没有那么迅捷。
5.补充内容:该患儿并未溺水或呛水。
事实上,儿童河水中少量呛水并不少见,较少有证据表明少量呛水易带来严重感染,尤其在缺乏基础疾病情况下。
知识拓展
血源性金黄色葡萄球菌性肺炎具有一些临床和影像学特征:
1.起病急,临床症状重;
2.表现多样,多种影像表现可同时出现,如斑片状影、小点状影、结节影、肺气囊等可在CT片上同时见到;
3.病灶比较广泛,多个肺野出现同时受累;
4.容易在短期内出现散在的肺气囊或多发的脓肿病灶;
5.病灶易变,短期内复查CT可见病灶的形态、部位、大小发生变化。



金黄色葡萄球菌肺炎CT征象 来源放射沙龙
南边课堂-关于血源性金葡菌肺炎
一、影像特点
1.外围分布,胸膜下为主,两肺弥漫结节或胸膜下楔形影,边界清,周围伴有GGO

2.反晕征:往往紧贴胸膜,并且胸膜侧无环,周围GGO

3.空洞:分为两类。
第一类,偏心空洞,一侧壁厚,周围实变明显。
第二类,薄壁空洞(偏中后期):壁薄且均匀,内外壁光滑,张力高,内有气液平面、间隔影,各空洞相对独立互不相通

4.囊:张力高,壁薄,内外壁光滑,可有间隔

5.边缘收缩明显,结节密实,边缘收缩、凹陷,周围长索条影,提示吸收好转

6.胸腔积液、脓胸

7.增强可见肺动脉栓子(少见)

二、鉴别诊断
1.血道侵袭性曲霉菌病



2.转移瘤

3.血行播散性肺结核


课件来源:第七期胸部影像诊断学习班-《金葡菌肺炎影像特点》潘军平老师
 纵隔大细胞神经内分泌癌1例CT影像
纵隔大细胞神经内分泌癌1例CT影像  张力性纵隔气肿影像表现及严重度分级
张力性纵隔气肿影像表现及严重度分级  迅速增大的肺部结节,首先考虑良性,确诊需要肺穿
迅速增大的肺部结节,首先考虑良性,确诊需要肺穿  肺隔离症:易误诊为肺癌的占位性病变,肺穿刺禁忌!
肺隔离症:易误诊为肺癌的占位性病变,肺穿刺禁忌!  肺段与肺内管道应用解剖
肺段与肺内管道应用解剖  肺转移瘤的十种不典型CT表现
肺转移瘤的十种不典型CT表现  肺内淋巴结的CT表现特点及与病理对照
肺内淋巴结的CT表现特点及与病理对照  肺实变与肺不张的CT鉴别诊断
肺实变与肺不张的CT鉴别诊断  医生现身说法,这五种忙帮不得!
医生现身说法,这五种忙帮不得!  北大教授:要真正让医务人员有阳光体面的收入!医
北大教授:要真正让医务人员有阳光体面的收入!医  为值夜班的医生护士鼓与呼:请给我们更多关注!
为值夜班的医生护士鼓与呼:请给我们更多关注!  广东拟取消医院用药数量限制,满足患者多样性需求
广东拟取消医院用药数量限制,满足患者多样性需求  博士、硕士入职就给精装房!又有医院不惜下血本招
博士、硕士入职就给精装房!又有医院不惜下血本招  历时7年之久,温医生宣判无罪!
历时7年之久,温医生宣判无罪!  重磅!四川发文:严禁限制医生多点执业
重磅!四川发文:严禁限制医生多点执业  与真人医生诊断一致性达96%:AI医生应用前景广阔
与真人医生诊断一致性达96%:AI医生应用前景广阔 



